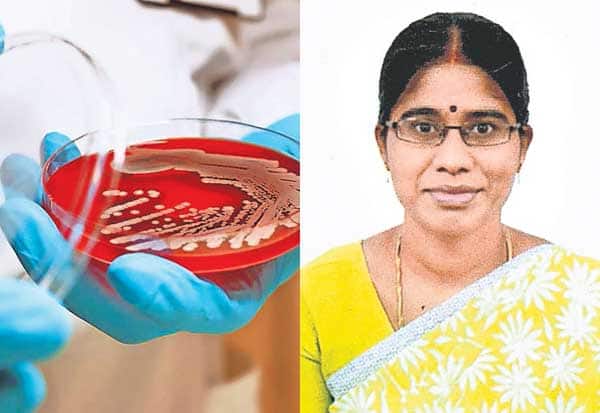
Latest Tamil News

PUBLISHED ON : நவ 30, 2025
அலெக்சாண்டர் பிளமிங் என்ற ஸ்காட்லாந்து நாட்டு விஞ்ஞானி, பென்சிலின் என்ற முதல் ஆன்டிபயாடிக் மருந்தை 1928ம் ஆண்டு கண்டுபிடித்தார். இரண்டாம் உலகப் போரில் காயமடைந்து தொற்றுக்கு ஆளான ஆயிரக்கணக்கான போர் வீரர்களை, இந்த ஆன்டிபயாடிக் மருந்தே குணப்படுத்தியது. அதனால, 'மேஜிக் புல்லட்' என்று கொண்டாடப்பட்டு, உலகம் முழுதும் பெரிதும் பயன்பாட்டுக்கு வந்தது. அதன் பின், பல ஆன்டிபயாடிக் மருந்துகள் கண்டுபிடிக்கப்பட்டன. இந்த மருந்துகளை பயன்படுத்தி, நோய் தொற்றுகளை குணப்படுத்த முடிந்தது.
தங்களின் இருப்பை நிலைநிறுத்திக் கொள்ளும் உந்துதல் இயல்பாகவே உயிரிகளுக்கு உண்டு. இந்நிலையில், நுண்ணுயிரிகள் இந்த மேஜிக் புல்லட்டின் பிடியில் இருந்து தப்புவதற்கு பல காரணிகளை உருவாக்கி, இன்று பயன்பாட்டில் இருக்கும் அனைத்து ஆன்டிபயாடிக் மருந்துகளையும் எதிர்க்கும் வீரியம் மிக்க 'சூப்பர் பக்ஸ்' நுண்ணுயிரிகளாக வளரத் துவங்கிவிட்டன.
கடந்த 2019ம் ஆண்டில் ஆன்டிபயாடிக் மருந்துகளை எதிர்க்கும் திறனுள்ள கிருமி தொற்றால், உலகம் முழுவதிலும் 4.95 மில்லியன் மக்கள் இறந்துள்ளனர். மற்ற காரணிகளால் இறந்தவர்களை விடவும் இது அதிகம்.
நவீன மருத்துவ தொழில்நுட்பமாக இருக்கலாம்; திறமைமிக்க மருத்துவராக இருக்கலாம்; வசதி வாய்ப்புகள் இருக்கலாம். ஆனால், எந்த மருந்துக்கும் கட்டுப்படாத நோய் தொற்று ஏற்பட்டு விட்டால், என்ன செய்ய முடியும்?
உலக நுண்ணுயிரி எதிர்ப்பை கண்காணிக்கும் அமைப்பில் நம் நாடு 2019ம் ஆண்டில் இணைந்துள்ளது.
இதற்கென தேசிய செயல் திட்டத்தில், பெருகும் நுண்ணுயிரி நிவாரண எதிர்ப்பு குறித்து விழிப்புணர்வை ஏற்படுத்துவது, கண்காணிப்பை மேம்படுத்துவது, ஆன்டிபயாடிக் பயன்பாட்டை முறைப்படுத்துவது, சுகாதாரத்தை பேணி தொற்றை தவிர்ப்பது போன்ற நெறிமுறைகள் பரிந்துரைக்கப்பட்டு உள்ளன.
ஆன்டிபயாடிக் எதிர்ப்பு எவ்வாறு பரவுகிறது? தடுக்க என்ன செய்ய வேண்டும்?
சளி, இருமல், காய்ச்சல் போன்ற உபாதைகள் ஏற்பட்டால் என்ன செய்கிறோம்?
பெரும்பாலும் மருத்துவர் பரிந்துரைத்த பழைய மருந்து சீட்டை காண்பித்து மருந்து வாங்குவது, மருந்து கடையில் நாமாகவே மருந்து வாங்கி சாப்பிடுவது,
இதற்கு முன் இதே பிரச்னை வந்த போது, வாங்கிய மிஞ்சிய மாத்திரைகளை பயன்படுத்துவது என்று இதில் ஏதோ ஒன்றை தான் செய்கிறோம்.
மருந்து அட்டையில் சிவப்பு கோடிட் ட மாத்திரைகளை மருத்துவரின் பரிந்துரை இல்லாமல் எடுத்துக் கொள்ளக் கூடாது என்பதோ, ஆன்டிபயாடிக் மருந்துகள், மருத்துவரின பரிந்துரை சீட்டு இல்லாமல் விற்கக் கூடாது என்பதோ நமக்கு தெரிவதில்லை. அவசியம் இல்லாமல் ஆன்டிபயாடிக் மருந்துகளை உபயோகிப்பது, அவற்றிற்கு எதிராக நுண்ணுயிரிகளிடம் ஆன்டிபயாடிக் எதிர்ப்பு உருவாக காரணமாக உள்ளது.
இது தவிர, ஆன்டிபயாடிக் மருந்துகளை மருத்துவரின் பரிந்துரையின்றி, பரிந்துரைத்தபடி முழுமையாக அளவு, நாட்கள் எடுத்துக் கொள்ளாமல் நிறுத்தி விடுவதாலும், நுண்ணுயிரிகள் ஆன்டிபயாடிக் மருந்துகளை எதிர்க்கும் திறனை பெறுகின்றன.
இதனால், முன்பை காட்டிலும் வீரியம் மிக்க நுண்ணுயிரிகளாக உருமாற்றம் அடைகின்றன.
ஆன்டிபயாடிக் மருந்துகளின் முறையற்ற பயன்பாடுகளை தடுப்பதற்கான சட்டமியற்றி, மக்களுக்கு விழிப்புணர்வை ஏற்படுத்துவதில் கேரள அரசு முன்னோடியாக உள்ளது.
தமிழ்நாடு மருத்துவக் கல்வி ஆராய்ச்சியகம், நம் மாநிலத்திற்கான ஆன்டிபயாடிக் கொள்கையை வெளியிட்டு உள்ளது. மருத்துவம் சாரா காரணங்களுக்காக ஆன்டிபயாடிக் மருந்துகளின் உபயோகத்தை தடுக்க சட்டங்கள் இருந்தாலும், அ வை முழுமையாக நடைமுறையில் இல்லை என்பதே யதார்த்தம்.
டாக்டர் உஷா கிருஷ்ணன்,பேராசிரியை, நுண்ணுயிரியல் துறை,மெட்ராஸ் மெடிக்கல் காலேஜ்,சென்னை.போன்: 98848 24617மெயில்: ushakrishnan72@gmail.com

